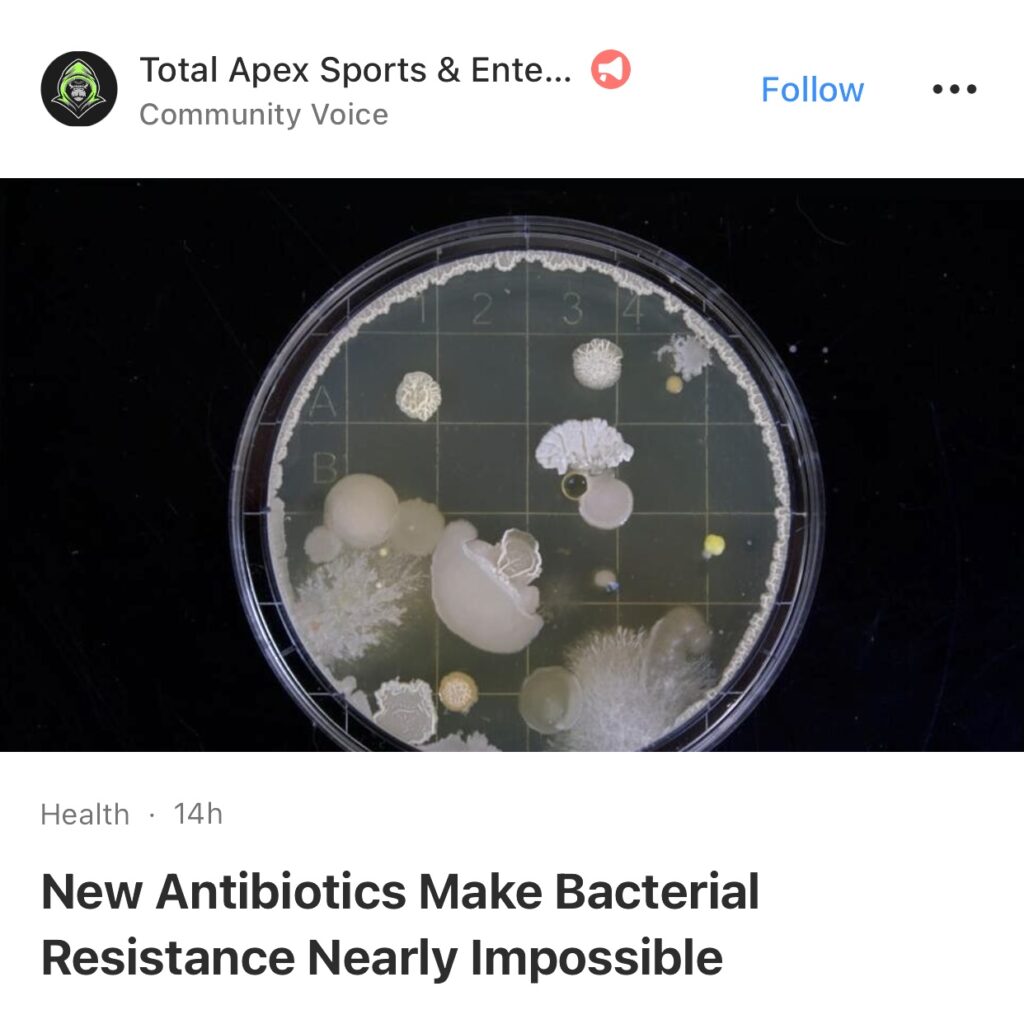

1。据The Hill报道,美国周二宣布向菲律宾投资 5 亿美元,以帮助菲律宾武装部队和海岸警卫队实现现代化,因为马尼拉在印度太平洋争议海域面临来自中国的日益严重的威胁。

2。据台湾台北美联社报道,台湾总统赖清德欢迎他所称的“有史以来最大规模”的外国议员代表团访问台湾,并于周二表示,这表明了民主国家团结的重要性。

3。据Business Insider美国正在向乌克兰提供与其F-16战机配套的先进导弹和炸弹。

4。据基辅路透社报道,基辅外交部周二表示,乌克兰已邀请中国外交部长访问,对话不断加强,最终可能导致两国最高领导人举行会晤。

5。据Scripps News报道,世界卫生组织希望利用新冠疫苗技术开发新型禽流感疫苗。

6。据Total Apex Sports报道,新抗生素使细菌几乎不可能产生耐药性。Clavobactin几乎可以消除与疾病相关的继发感染。它还可以预防妨碍日常生活和住院的并发症。它正在塑造现代医学,并为更多拯救生命的发现铺平道路。
7。据The Independent报道,台湾总统赖清德警告称,中国入侵台湾所造成的全球影响将会比弗拉基米尔·普京对乌克兰的战争或新冠疫情造成的影响更严重。

8。据TheKoreanDaily 报道,金正恩的大胆举动:朝鲜外交官被告知不要理会中国。据报道,在朝鲜与中国之间摩擦的迹象日益增多的情况下,朝鲜领导人金正恩已指示驻华朝鲜外交官停止关注中国当局。此举出台之际,朝鲜似乎通过限制中国公民在朝鲜境内的行动来公开挑战中国。

9。据SciTechDaily 报道,阿拉斯加冰川融化加速,逼近不可逆转的临界点。“令人难以置信的担忧”。

10。据北京路透社报道,据官方新华社周三报道,中国国家主席习近平呼吁建设强大的边防、海防、空防,以保护国家领土主权和海洋利益。新华社援引习近平周二在中共中央政治局集体学习会上的话说,边海空防御是中国主权的重要象征,是国家发展的重要保障。

11。据CNBC 报道,在有报道称美国将免除盟友对中国芯片的新限制后,ASML股价上涨7%。

12。据罗马/北京路透社报道,意大利总理乔治亚·梅洛尼周日誓言要“重新启动”与中国的合作,并在上任以来首次正式访问北京期间签署了一项三年行动计划。

13。据ESPN报道,奥运会:阿根廷、埃及、摩洛哥进入足球四分之一决赛。

14。据Newsweek 报道,伊朗哈梅内伊发誓要对以色列杀害哈马斯政治领袖进行报复。哈梅内伊在其官方网站上发表声明称,“我们认为他的复仇是我们的责任”,并称哈尼亚是“我们家里的一位亲爱的客人”。

15。据北京路透社报道,中国领导人周二表示,实现今年经济增长目标所需的刺激措施将针对消费者,这与他们向基础设施项目注入资金的惯常做法不同。

以下为华人服务广告区:





如果大家喜欢“简报”,希望登陆网站americannewsdigest24.com, 点击小铃铛订阅,每月仅$2美元。有你们的支持我会把“简报”办得更好。谢谢!
顾震帝 2024年,8月,01日。

lamerler olmez
roketbet
certainly like your website but you need to take a look at the spelling on quite a few of your posts Many of them are rife with spelling problems and I find it very troublesome to inform the reality nevertheless I will definitely come back again
Eu acredito que todas as idéias que você apresentou para sua postagem são realmente convincentes e certamente funcionarão. No entanto, as postagens são muito curtas para novatos. Você pode, por favor, alongá-las um pouco nas próximas vezes. Obrigado pela postagem
So unique